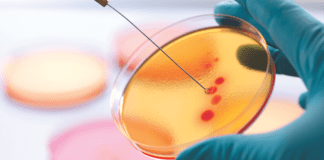
Report: Anti-microbial resistance analysis in Indian Aquaculture

Impact of Climate Change on Livestock Farming
Abstract
Global demand for livestock products is expected to double by 2050, mainly due to improvements in the worldwide standard of living. Climate change impacts...
Process Optimization in Cattle feed
Think Grain Think Feed connected with Mr. Ramamoorthy Sundaram, RGS Feeds to get some tips on process optimization in cattle feed manufacturing. Below are...
Dealing with variations in feed
The extremely volatile RM price situation due to various reasons has resulted in a huge spike in livestock feeding costs and this seems to...
Fish-feed industry turns to krill, with unknown effects on the Antarctic...
The Antarctic krill fishing industry has been growing in the past two decades which is an alternative to wild fish in fish feeds, amid...
Report: Anti-microbial resistance analysis in Indian Aquaculture
A two-decade analysis of anti-microbial resistance from aquaculture and fisheries in Asia shows Andhra Pradesh, Kerala, and Tamil Nadu have emerged as multi-drug-resistant hotspots....
Another GM crop gets clearance for commercial use in India
A genetically modified (GM) hybrid variety of mustard has been approved for commercial cultivation by India's biotech regulator. Once approved by the environment ministry,...
Feed ingredients can contribute to global methane pledge by 2030
Is a seaweed feed additive that can significantly reduce methane emissions considered a feed ingredient or animal drug? What about an animal food ingredient...
UK – Trading plan to increase animal feed ingredient imports from...
The United Kingdom has launched a new trading plan — the Developing Countries Trading Scheme (DCTS) — to provide UK businesses with access to...
Mango pulp & poultry feed
Some students at Gulu University's Faculty of Agriculture and Environment will learn how to use mango pulp that hasn't been sold to make chicken...
Vets In Poultry 4th AGM & Symposium Paradigm of possibilities and...
Date: August 27, 2022 & Aug 28, 2022
Vets In Poultry, an association based in Pune, has more than 1000 members actively working in Poultry...